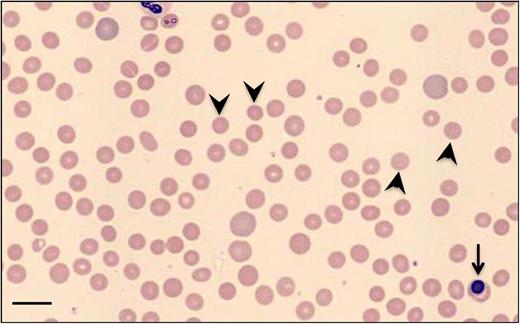
Figure 1. Blood smear of a patient with w-AIHA on presentation. Polychromasia reflecting reticulocytosis, many microspherocytes (few pointed by arrowheads), and a nucleated red blood cell (arrow), indicating stress erythropoiesis, are noted (Wright-Giemsa stain). Bar represents 14 μm.

Abstract
Autoimmune hemolytic anemia (AIHA) is a rare and heterogeneous disease that affects 1 to 3/100 000 patients per year. AIHA caused by warm autoantibodies (w-AIHA), ie, antibodies that react with their antigens on the red blood cell optimally at 37°C, is the most common type, comprising ∼70% to 80% of all adult cases and ∼50% of pediatric cases. About half of the w-AIHA cases are called primary because no specific etiology can be found, whereas the rest are secondary to other recognizable underlying disorders. This review will focus on the postulated immunopathogenetic mechanisms in idiopathic and secondary w-AIHA and report on the rare cases of direct antiglobulin test–negative AIHA, which are even more likely to be fatal because of inherent characteristics of the causative antibodies, as well as because of delays in diagnosis and initiation of appropriate treatment. Then, the characteristics of w-AIHA associated with genetically defined immune dysregulation disorders and special considerations on its management will be discussed. Finally, the standard treatment options and newer therapeutic approaches for this chronic autoimmune blood disorder will be reviewed.
Learning Objectives
Discuss the immunopathogenesis of autoantibody production and the mechanisms of antibody-sensitized red blood cell destruction in warm autoimmune hemolytic anemia (w-AIHA)
Understand the reasons DAT may be negative in some cases of w-AIHA and the implications in diagnosis and management of these cases
Recognize the association of w-AIHA with autoimmune lymphoproliferative syndrome (ALPS) and other primary immunodeficiency (PID) syndromes
Review the standard treatment options and newer therapeutic approaches for w-AIHA
Normal red blood cells (RBCs) have an average life span of 115 days.1 Hemolysis is defined as decreased RBC survival and can be caused because of an inherent abnormality of the cell (intrinsic or intracorpuscular defect), by extrinsic factors, or by a combination of both. When hemolysis occurs at a rate that cannot be compensated by increased RBC production, then the patient presents with hemolytic anemia. The premature RBC destruction can happen intravascularly or extravascularly in the reticuloendothelial system (mainly adjacent to the macrophages of spleen and liver) and can be episodic/acute or chronic. Clinical presentation includes pallor, fatigue, jaundice, dark urine, splenomegaly, and, in chronic cases, gallstones and cholecystitis. Common laboratory findings are anemia, ie, decreased hemoglobin (Hb), reticulocytosis, elevated unconjugated bilirubin and lactate dehydrogenase, serum aspartate aminotransferase disproportionately higher than serum alanine aminotransferase, and decreased haptoglobin.
Autoimmune hemolytic anemia (AIHA) is caused by increased RBC destruction triggered by autoantibodies reacting against RBC antigens with or without complement activation.2,3 The autoantibodies and/or complement fragments are detected on the RBC surface using the direct antiglobulin test (DAT). DAT, or direct Coombs test, is typically performed in 2 steps. First, the polyspecific reagent containing both anti-immunoglobulin G (IgG) and anticomplement is used to agglutinate antibody-coated cells, and then the monospecific reagents anti-IgG and anti-C3d (anti-C3b, anti-C4b, and anti-C4d reagents also available) are used individually to detect IgG and complement, respectively. Binding of anti-C3d alone often indicates bound IgM.4,5 AIHA is classified into 3 major types based on the optimal temperature in which the autoantibodies bind on the patient’s RBCs in vivo: warm antibody AIHA (w-AIHA), cold agglutinin syndrome (CAS), and paroxysmal cold hemoglobinuria (PCH). In some unusual cases, considered as “mixed AIHA,” the laboratory data satisfy the serologic criteria of both w-AIHA and CAS.6 The 2 clinical entities of AIHA that are due to cold-reacting autoantibodies are defined by the immunoglobulin isotype against the RBCs: IgM in CAS and IgG in PCH. IgM autoantibodies, typically directed against the I/i system of RBC antigens, are maximally reactive in the cold (4°C), although they may keep a reactivity up to ≥30°C (wide “thermal amplitude”). The IgM pentamers fix complement much more readily than IgG, causing intravascular hemolysis and to a lesser extent extravascular lysis mainly in the liver by macrophages with C3d receptors. Rouleaux formation indicating RBC agglutination is frequently noted on the blood smear. PCH is caused by the Donath-Landsteiner IgG antibodies which are usually directed against the P antigen of RBCs. Donath-Landsteiner antibodies are biphasic hemolysins: they bind to RBCs and fix complement (C1) at cold temperatures, but the complement is then activated at the core temperature of 37°C causing intravascular RBC lysis. PCH is frequently postinfectious and typically has a good prognosis after remission; however, it can be life threatening on presentation due to severe and rapidly progressive anemia.3,7
AIHA is a rare disease with an incidence of 1 to 3 per 100 000 people per year.8,9 w-AIHA is the most common type of autoimmune hemolytic anemia, comprising ∼70% to 80% of all adult cases and ∼50% of the pediatric cases.9 About half of the w-AIHA cases are called primary because no specific etiology can be found, whereas the rest are recognized as secondary to lymphoproliferative syndromes; malignant diseases including chronic lymphoblastic leukemia (CLL), non-Hodgkin’s lymphoma, and solid tumors; rheumatologic diseases, especially systemic lupus erythematosus; infections (mostly viral)10,11 ; drugs; frequent cephalosporins and piperacillin; or a previous transfusion or transplantation.3 The category of primary or idiopathic (ie, of unknown cause) w-AIHA is likely to keep shrinking in the near future as we increasingly recognize more monogenic and polygenic disorders of immune dysregulation, which frequently have an autoimmune cytopenia as their first manifestation.
In w-AIHA, the autoantibodies react optimally with the RBCs at 37°C. Typically, no autoantibody specificity can be identified; the autoantibodies are polyclonal and react with all RBCs tested (pan-reactive), even when w-AIHA complicates a clonal B-cell lymphoproliferative disorder like CLL. Microspherocytes are frequently noted on the blood smear (Figure 1). Polychromasia, indicating reticulocytosis, is typical, although the reticulocyte count may not be elevated early in the course, and occasionally relative reticulocytopenia may be continuously observed as a result of autoantibody sensitization and destruction of late erythroid precursors. Complement activation on the RBC surface may lead to the formation of membrane attack complex (C5b9), causing RBC lysis in the circulation, although this is more typical for antibodies that avidly bind complement like the IgM pentamers in CAS. Intravascular complement-mediated cell lysis does not play a significant role in most patients with w-AIHA, implicating that terminal complement inhibitors would be clinically irrelevant,12 except maybe for those atypical cases with significant warm antibody-complement–mediated intravascular hemolysis.13 Erythrocytes coated by warm-reacting IgG are bound by spleen macrophages, which carry Fcγ receptors for the IgG heavy chain, and they are either phagocytosed or have part of their membrane removed, in which case they form microsperocytes subject to further destruction during their next passage through the spleen. Antibody-dependent cell-mediated cytotoxicity (ADCC), mediated by cytotoxic CD8+ T cells and natural killer (NK) cells also with Fc receptors in the spleen, also contributes to RBC destruction/extravascular hemolysis. When either a high concentration of IgG or IgG with high affinity to complement is bound to the erythrocytes, complement (C1q) is bound and gets activated toward C3b. C3b-opsonized RBCs are next phagocytosed by liver macrophages that carry C3b receptors (Figure 2).3,12,14
Blood smear of a patient with w-AIHA on presentation. Polychromasia reflecting reticulocytosis, many microspherocytes (few pointed by arrowheads), and a nucleated red blood cell (arrow), indicating stress erythropoiesis, are noted (Wright-Giemsa stain). Bar represents 14 μm.
Blood smear of a patient with w-AIHA on presentation. Polychromasia reflecting reticulocytosis, many microspherocytes (few pointed by arrowheads), and a nucleated red blood cell (arrow), indicating stress erythropoiesis, are noted (Wright-Giemsa stain). Bar represents 14 μm.
Mechanisms of antibody-sensitized RBC destruction in w-AIHA. Erythrocytes coated by warm-reacting IgG are bound by spleen macrophages carrying Fcγ receptors for the IgG heavy chain, and they are either phagocytosed or have part of their membrane removed, in which case they form microspherocytes subject to further destruction during their next passage through the spleen. ADCC, mediated by cytotoxic CD8+ T cells (Tc) and NK cells, is also contributing to extravascular hemolysis preferentially in the spleen and lymphoid organs. When either a high concentration of IgG or IgG with high affinity to complement is bound to the erythrocytes, complement (C1q) is bound and gets activated toward C3b. C3b-opsonized RBCs are next phagocytosed by liver macrophages that carry C3b receptors.
Mechanisms of antibody-sensitized RBC destruction in w-AIHA. Erythrocytes coated by warm-reacting IgG are bound by spleen macrophages carrying Fcγ receptors for the IgG heavy chain, and they are either phagocytosed or have part of their membrane removed, in which case they form microspherocytes subject to further destruction during their next passage through the spleen. ADCC, mediated by cytotoxic CD8+ T cells (Tc) and NK cells, is also contributing to extravascular hemolysis preferentially in the spleen and lymphoid organs. When either a high concentration of IgG or IgG with high affinity to complement is bound to the erythrocytes, complement (C1q) is bound and gets activated toward C3b. C3b-opsonized RBCs are next phagocytosed by liver macrophages that carry C3b receptors.
This review will describe the postulated pathogenetic mechanisms in idiopathic and secondary w-AIHA, report on the rare cases of DAT-negative AIHA and on cases associated with genetically defined immune dysregulation, and discuss standard treatments and new therapeutic approaches.
Pathogenetic mechanisms in idiopathic and secondary w-AIHA
Autoantibodies, the complement system, phagocytes, cytotoxic CD8+ T cells and NK cells performing ADCC, B and T lymphocytes including the CD4+ T regulatory (Treg) cells, and cytokines are all key players in the pathogenesis of w-AIHA. Several mechanisms leading to breach of normal interactions between these immune system components have been proposed and are being actively investigated as responsible for the breakdown of immunologic tolerance that allows development of w-AIHA.3,6 An excellent recent review by Barcellini3 describes in detail the working hypotheses and relevant data on these mechanisms.
Molecular mimicry of foreign antigens from viruses or other exogenous infectious and noninfectious agents, eg, drugs, that cross-react with RBC self-antigens, most frequently Rh proteins, and occasionally glycophorins and band 3, may overcome self-tolerance and trigger AIHA. Additionally, polyclonal activation of B lymphocytes by viruses may trigger the emergence of “forbidden clones,” occasionally along with a congenital or acquired lymphoproliferative disorder.
The CD4+ T-helper cell subsets, Th1, Th2, Th17, and the Tregs control the humoral immune system and have a critical role in maintaining or losing self-tolerance. Elevated frequency of Th17 cells producing increased interleukin-17 (IL-17) were found to correlate with disease activity in patients with AIHA.15 CD4+CD25+ Treg cells express high levels of the IL-2 receptor CD25 and secrete transforming growth factor-β and IL-10. Naturally occurring Tregs contribute to immunologic self-tolerance by suppressing potentially autoreactive T cells. Treg cells were indeed found reduced in patients with AIHA.16 Imbalance between Th1 and Th2 cells and the cytokines they secrete may also play a role. Th1 secrete IL-2, IL-12, interferon-γ, and tumor necrosis factor-β and promote cell-mediated immunity, whereas Th2 cells secrete IL-4, IL-5, IL-6, IL-10, and IL-13 and promote humoral responses. Although the data on increased and decreased cytokine levels in patients with AIHA may be somewhat conflicting, they favor that a reduced Th1 and a prominent Th2 profile promote the pathogenesis of AIHA.3,6
Regarding unique mechanisms in secondary w-AIHA, a decrease of the CR1 complement receptor (CD35) and CD55 (decay-accelerating factor) or CD59 was found on RBCs and CD3+ lymphocytes in systemic lupus erythematosus–associated AIHA, whereas after bone marrow transplantation, an activation of host self-reactive B cells by allo-reactive donor T cells was seen in chronic graft-versus-host disease.6
Further investigation and understanding of the immunopathogenetic mechanisms that lead to AIHA will provide insights for development of more effective and less toxic, targeted therapeutic options.
DAT-negative AIHA
In 1957, Evans and Weiser reported on the serology of immune hemolytic disease, describing 41 cases of autoimmune hemolytic anemia, 4 of which had negative direct and indirect Coombs.17 In 1 case, RBC agglutination in the DAT was achieved only after preparing the antiglobulin serum by injecting the patient’s own serum into rabbits. In the other 3 cases, the 2 associated with infectious mononucleosis, autoantibodies or isoantibodies, could not be demonstrated but transfused RBCs in these patients had a severely decreased survival, indicating that a factor extrinsic to the patients’ red cells was responsible for their destruction. Since then, numerous case series have studied anemia with clinical characteristics of w-AIHA but with negative DAT. Based on such publications, the incidence of DAT-negative w-AIHA has been estimated at 3% to 11% of all cases, depending, at least in part, on the potency of the direct antiglobulin reagent used for the DAT.18
There are several inherent characteristics of the RBC autoantibodies causing DAT-negative w-AIHA, and thankfully there are now alternative methods to prove their existence, which are easier and faster than immunizing a rabbit with the patient’s serum.
Anti-RBC IgG may bind to the erythrocytes at relatively low levels causing hemolysis but being below the threshold of detection for the commonly used DAT reagents. Kamesaki et al studied samples from 154 patients with DAT-negative AIHA and from 62 patients with DAT-positive disease by immunoradiometric assay and determined that the first group had a mean red cell IgG density approximately an order of magnitude less (179 IgG molecules/red cell) than in DAT-positive patients (1397 IgG molecules/red cell).19 Normal RBCs from healthy control subjects had been previously determined to have a low level of IgG adsorbed on their membrane, calculated at 33 ± 13 molecules/cell as detected by immunoradiometric assay20 or <35 molecules/cell as detected by complement-fixing, antibody consumption test.21 At the same time, the commercial DAT reagent and assay could not identify positivity below ∼500 molecules of IgG/cell.21 Flow cytometry assays have been now developed and used by reference laboratories; they are calibrated so that the fluorescently labeled anti-human IgG on red cells is detected at a sensitivity greater than that of the commercial DAT reagent, decreasing the frequency of a false-negative antiglobulin test.18,22,23
RBC autoantibodies may have low affinity and therefore are removed easily from the red cell surface during preparative washings of the cells at room temperature, to perform direct Coombs. Cold washing with isotonic or with low ionic strength saline at 4°C using refrigerated centrifuges can prevent the antibody loss from the RBC surface, improving the sensitivity of the commercial DAT assay.18,24
w-AIHA may be rarely due to sensitization of RBCs with IgA25,26 or a warm-reacting, monomeric IgM alone instead of IgG, without complement fixation,27 in which cases most commercial DAT reagents, containing only anti-IgG against the γ heavy chain portion of the IgG molecule and anti-C3, are not detecting the antibodies.5
Reference laboratories are offering enhanced DAT assays (orderable frequently as super-Coombs or micro-Coombs), using an extensive list of methods reviewed in detail by Segel and Lichtman,18 to confirm the immune basis of a hemolytic anemia with history and clinical and hematologic findings compatible with w-AIHA but with negative routine DAT. Of note, in keeping with the observations that the intensity of DAT reaction does not correlate with the degree of hemolysis and severity of the disease, DAT-negative w-AIHA can be mild or severe and life threatening. Similarly to the DAT-positive disease, DAT-negative w-AIHA can also be primary or secondary, may respond to steroids or splenectomy or may not, and requires the same management approach.28-30
AIHA associated with genetically defined immune dysregulation
wAIHA presenting either simultaneously or sequentially with thrombocytopenia is known as Evans syndrome.31 In fact, when Robert Evans and his colleagues described in 1951 the combination of primary thrombocytopenic purpura (of unknown origin at the time pathogenesis) with acquired hemolytic anemia (which was known to be due to red cell sensitization with antibodies) gave, for the first time, evidence that the primary (or idiopathic) thrombocytopenic purpura is of autoimmune etiology similar to the concurrent hemolytic anemia.31 This combination came later to be known as Evans syndrome. Over time, the definition of the syndrome has expanded to cover the combination of any 2 or 3 autoimmune cytopenias and is increasingly recognized to be a manifestation of common variable immunodeficiency with autoantibody formation due to defective B-cell selection and maturation, or of autoimmune lymphoproliferative syndrome (ALPS), a classic primary immunodeficiency (PID), or of other novel immune dysregulation syndromes.32-34 Therefore, the diagnosis of Evans syndrome should trigger a basic immunologic workup including screening for common variable immunodeficiency and ALPS. In fact, childhood AIHA is frequently secondary to an immunologic disease. In a series of 265 children with AIHA (French National Observational Study), the diagnosis of AIHA followed a diagnosis of another autoimmune disease, including immune thrombocytopenic purpura (ITP), or a PID in 15% of the cases (41 of 265), whereas an additional 38% of the cases (100 of 265) was recognized later to be of immunological origin with an additional autoimmune disease or PID diagnosis in follow-up. Moreover, 47% (23 of 49) of the children who were thought to have a postinfectious AIHA at the time of diagnosis, with a well-documented history of infection, turned out to have immunologic conditions.10 Therefore, any pediatric autoimmune cytopenia should elicit investigation for family history of autoimmunity (it is always revealing when a parent on questioning reports history of autoimmune cytopenia or chronic lymphadenopathy or splenomegaly) and consideration for an underlying immune dysregulation.
ALPS is caused by germline or occasionally somatic mutations in the genes FAS, FASL, or CASP10, resulting in impaired Fas-mediated lymphocyte apoptosis that allows survival of activated autoreactive lymphocytes.35-37 Its first manifestation in childhood is frequently a chronic autoimmune cytopenia, usually ITP or w-AIHA, with variable degrees of lymphadenopathy and splenomegaly. Hypersplenism is occasionally contributing to cytopenias. Patients with ALPS may develop more autoimmune manifestations, including uveitis, hepatitis, glomerulonephritis, and interstitial lung disease with lymphocytic infiltrates, whereas they are also at increased risk for malignancy, mainly lymphomas. Therefore, high index of suspicion for malignancy is recommended at any age when an ALPS patient presents with refractory cytopenias.36 With the advent of whole exome sequencing, mutations in several genes critical for immune cell biology, including NRAS, KRAS, MAGT1, CASP8, FADD, PRKCD, CTLA4, LRBA, PI3K, and STAT3, have been identified and validated over the last few years as the cause of novel PID syndromes, each one with its own particular clinical and laboratory characteristics and a variable possibility for autoimmune cytopenias.34,36,38
Autoimmune hemolytic anemia developing as a manifestation of PID tends to be chronic and refractory. Although corticosteroids with or without intravenous immunoglobulin (IVIG) are frequently an effective first-line treatment, second- and third-line treatments are typically required to avoid the side effects of chronic corticosteroid use. The management of ALPS patients in clinical trials has provided valuable insights for the management of refractory AIHA and/or ITP in patients with an underlying immunodeficiency either defined by a known gene mutation or one yet to be determined.35,36,39 It is important to note that splenectomy should be a last resort in the management of cytopenias in ALPS because overwhelming sepsis following splenectomy is the most frequent cause of death in these patients, even more frequent than malignancies.36,40 The defective B-cell function in ALPS was found to be associated with poor anti-polysacharide IgM antibody production,41 predisposing the patients to a higher risk of life-threatening pneumococcal sepsis after splenectomy, up to 41% in a cohort of splenectomized ALPS patients.36 Rituximab also demonstrated increased toxicity in ALPS patients causing prolonged and severe hypogammaglobulinemia up to lifelong IVIG dependency.35,36 Mycophenolate mofetil (MMF) and sirolimus are currently the agents of choice for second-line treatment of ALPS-related cytopenias, with sirolimus having a beneficial effect even to the spleen and lymph node size.36,39
Standard treatment options and new therapeutic approaches
The rarity and heterogeneity of w-AIHA essentially preclude randomized prospective phase 3 trials to provide evidence-based recommendations. The treatment algorithms are based on data from retrospective reviews, case series, and from a few phase 2 prospective trials, as well as on expert experience and recommendations.42 There are certainly enough data and experience to conclude that w-AIHA can be a fatal disease, either because of the acuity of the presentation or because of being refractory to treatment with acute relapses requiring multiple lines of therapy with frequently life threatening complications. A mortality rate of 11% in adults and 4% in children has been reported.10,43
A recent retrospective study reviewed the course, laboratory data, treatment, and clinical outcome of 308 primary autoimmune hemolytic anemia (AIHA) cases (including 10 pediatric patients) over a follow-up period of 12 to 372 months (median, 33 months).44 Sixty percent of these patients, had w-AIHA, 27% had CAS, 8% had mixed (DAT positive for IgG and C3d with coexistence of warm autoantibodies and high-titer cold agglutinins), and 5% were atypical (mostly DAT-negative w-AIHA). The mixed and atypical cases presented frequently with severe onset (Hb <6 g/dL) along with reticulocytopenia. The level of Hb at presentation was predictive of the relapse risk, with the more severe cases (including mixed and atypical ones) having >50% cumulative incidence of relapse after 3 years or a threefold increased risk of relapse in comparison with the mild cases (Hb >10 g/dL) and requiring multiple lines of treatment.44 Table 1 provides an outline for a sequential approach to treatment options for w-AIHA, which is discussed in detail below.
Sequential approach to treatment options for w-AIHA and common dosing regimens
| Treatment option . | Common dosing regimens . |
|---|---|
| First-line treatment: with the goal to support and stabilize during acute hemolysis | |
| Steroids | The first 72 hours, dose varies widely between different hematology teams from 1 to 2 mg/kg/dose of prednisone every 8-12 hours up to high-dose steroids, eg, methylprednisolone 250-1000 mg/day |
| After the first 72 hours, the dose is decreased to 1-2 mg/kg/day in children and 30-80 mg/day in adults | |
| Disease is considered responsive to steroids if stabilization of Hb to >10 g/dL within 1-3 weeks | |
| After such a response, the steroid dosing should continue for ≥6 months with a very slow wean | |
| Transfusions | Establish good communication with transfusion services to provide as needed to treat anemia |
| IVIG | Usually 1 g/kg/day × 2 days; consider when response to steroids in the acute setting is not satisfactory |
| Plasmapheresis | Consider when response to steroids in the acute setting is not satisfactory |
| Second-line treatment: in refractory disease with no or limited response to steroids and/or when steroids cannot be weaned appropriately | |
| Rituximab | Most frequently 375 mg/m2 intravenously weekly for 4 weeks but decreased dose of 100 mg intravenously weekly for 4 weeks has also been effective; caution recommended in cases of underlying immune dysregulation, eg, ALPS |
| Splenectomy | Caution recommended in cases of underlying immune dysregulation, eg, ALPS |
| Second-line treatment: when steroids cannot be weaned appropriately | |
| MMF | 600 mg/m2 by mouth twice daily37 |
| Sirolimus | 2 mg/m2 by mouth once daily (goal trough 5-15 ng/mL)37 |
| Danazol (off-label) | Initial dosages ranged from 600 to 800 mg/day (by mouth in 3-4 divided doses), with maintenance therapy of 200-600 mg/day |
| Third-line treatment: when disease relapses or remains refractory despite 2nd line treatment | |
| Azathioprine | In pediatrics used typically for w-AIHA accompanied by autoimmune hepatitis, at initial dose of 0.5 mg/kg titrated to response up to 2 mg/kg by mouth once daily |
| Adults: 1-2 mg/kg (maximum, 150 mg daily) | |
| 6-Mercaptopurine | 50-75 mg/m2 by mouth once daily (2.5 mg/kg once daily for children with body surface area under 1 m2)53 |
| Cyclosporine | 5 mg/kg/day initially, decreased after response to 2-3 mg/kg/day by mouth divided every 12 hours |
| Cyclophosphamide | Dosing used in ITP has been 1-2 mg/kg/day orally for ≥16 weeks or 300-1000 mg/m2 intravenously for 1-3 doses every 2-4 weeks56 |
| Fourth-line treatment: high risk treatment to consider as last resort | |
| High-dose cyclophosphamide | 50 mg/kg/day for 4 days followed by granulocyte colony-stimulating factor43 |
| Alemtuzumab | 3 mg intravenously or subcutaneously on day 1 and then if tolerated, 10 mg on day 2, and then if tolerated, 30 mg on day 3, continue with maintenance 10-30 mg 3 times weekly for up to 12 weeks |
| HSCT | Autologous or allogeneic has been used |
| Treatment option . | Common dosing regimens . |
|---|---|
| First-line treatment: with the goal to support and stabilize during acute hemolysis | |
| Steroids | The first 72 hours, dose varies widely between different hematology teams from 1 to 2 mg/kg/dose of prednisone every 8-12 hours up to high-dose steroids, eg, methylprednisolone 250-1000 mg/day |
| After the first 72 hours, the dose is decreased to 1-2 mg/kg/day in children and 30-80 mg/day in adults | |
| Disease is considered responsive to steroids if stabilization of Hb to >10 g/dL within 1-3 weeks | |
| After such a response, the steroid dosing should continue for ≥6 months with a very slow wean | |
| Transfusions | Establish good communication with transfusion services to provide as needed to treat anemia |
| IVIG | Usually 1 g/kg/day × 2 days; consider when response to steroids in the acute setting is not satisfactory |
| Plasmapheresis | Consider when response to steroids in the acute setting is not satisfactory |
| Second-line treatment: in refractory disease with no or limited response to steroids and/or when steroids cannot be weaned appropriately | |
| Rituximab | Most frequently 375 mg/m2 intravenously weekly for 4 weeks but decreased dose of 100 mg intravenously weekly for 4 weeks has also been effective; caution recommended in cases of underlying immune dysregulation, eg, ALPS |
| Splenectomy | Caution recommended in cases of underlying immune dysregulation, eg, ALPS |
| Second-line treatment: when steroids cannot be weaned appropriately | |
| MMF | 600 mg/m2 by mouth twice daily37 |
| Sirolimus | 2 mg/m2 by mouth once daily (goal trough 5-15 ng/mL)37 |
| Danazol (off-label) | Initial dosages ranged from 600 to 800 mg/day (by mouth in 3-4 divided doses), with maintenance therapy of 200-600 mg/day |
| Third-line treatment: when disease relapses or remains refractory despite 2nd line treatment | |
| Azathioprine | In pediatrics used typically for w-AIHA accompanied by autoimmune hepatitis, at initial dose of 0.5 mg/kg titrated to response up to 2 mg/kg by mouth once daily |
| Adults: 1-2 mg/kg (maximum, 150 mg daily) | |
| 6-Mercaptopurine | 50-75 mg/m2 by mouth once daily (2.5 mg/kg once daily for children with body surface area under 1 m2)53 |
| Cyclosporine | 5 mg/kg/day initially, decreased after response to 2-3 mg/kg/day by mouth divided every 12 hours |
| Cyclophosphamide | Dosing used in ITP has been 1-2 mg/kg/day orally for ≥16 weeks or 300-1000 mg/m2 intravenously for 1-3 doses every 2-4 weeks56 |
| Fourth-line treatment: high risk treatment to consider as last resort | |
| High-dose cyclophosphamide | 50 mg/kg/day for 4 days followed by granulocyte colony-stimulating factor43 |
| Alemtuzumab | 3 mg intravenously or subcutaneously on day 1 and then if tolerated, 10 mg on day 2, and then if tolerated, 30 mg on day 3, continue with maintenance 10-30 mg 3 times weekly for up to 12 weeks |
| HSCT | Autologous or allogeneic has been used |
For danazol and most of the third- and fourth-line treatment medications, limited data are available; dosing regimen is based on case reports or small case series for patients with w-AIHA or dosages that have been used in patients with ITP.
The first-line treatment of w-AIHA includes glucocorticosteroids and likely transfusion. The first dose of steroids (1-2 mg/kg of prednisone orally or methylprednisolone intravenously) should be given immediately after the call that DAT is positive. If DAT is negative but the disease has the clinical and laboratory picture of w-AIHA, steroid treatment should also be initiated along with transfusion because the atypical cases of DAT-negative w-AIHA are also the ones with the higher risk of mortality, either due to precipitous hemolysis because of the antibody characteristics (eg, monomeric IgM causing w-AIHA) or because of the delay in treatment caused by the negative result of the routine DAT.19,27,43 It is important not to withhold RBC transfusion that can be life saving, especially in cases of brisk hemolysis and precipitous anemia. The pretransfusion serologic workup may be complicated by the presence of autoantibodies, but transfusion services can usually evaluate for underlying alloantibodies that may have developed as a result of previous transfusions or pregnancies. Good communication between the hematologist and the transfusion medicine physician is critical to assess and minimize the risks of transfusion in these settings.45,46 Of note, although reticulocytosis is a typical diagnostic finding in hemolytic anemia, up to 20% of adults and 39% of children with w-AIHA may present with reticulocytopenia, either due to inefficient erythropoietic response or due to autoantibody-mediated destruction of the late erythroblasts and reticulocytes. Such cases typically demonstrate significant anemia and require aggressive transfusion support to avoid a fatal outcome.43 Lechner and Jäger42 recommend an in vivo compatibility test when initiating a packed RBC transfusion in a patient with w-AIHA: rapid infusion of 20 mL blood followed by 20-minute observation. If no reaction is noted, then the rest of the unit is given at the usual speed.
The dose of steroids used the first 72 hours varies widely between different hematology teams from 1 to 2 mg/kg/dose of prednisone every 8 to 12 hours up to high-dose steroids, for example, 250 to 1000 mg/day methylprednisolone.32,42,43 After the first 72 hours, the dose is decreased to 1 to 2 mg/kg/day in children and usually to 30 to 80 mg/day in adults. About 80% of the patients with w-AIHA respond fairly well to steroids within 1 to 3 weeks,47 with stabilization of Hb to >10 g/dL. It is strongly advised that after a complete or partial remission, the steroid dosing continues for ≥6 months with a very slow wean. This prolonged steroid course significantly decreases the risk of relapse.43 A point to be made here is that, in contrast, steroids are not indicated in CAS, where they are rarely necessary or effective; if started in those cases, they should be aggressively weaned off.43 High-dose IVIG (usually 1 g/kg dose × 2 days) and plasmapheresis have been used in w-AIHA, although with inconsistent results, when response to steroids in the acute setting is not satisfactory.
Refractory patients, with no or limited response to steroids, require diagnostic reevaluation for an underlying disease, especially malignancy or rheumatologic disorders.42,43 Warm IgM AIHA also tends to be steroid refractory and the presence of these antibodies may have not been recognized if they exist in parallel to IgG in mixed w-AIHA. Control of the primary disease that has predisposed to the development of w-AIHA is typically necessary for improvement in hemolysis. Additionally, a second-line approach for AIHA will need to be considered in cases of refractory disease, which may be rituximab or splenectomy. Rituximab (anti-CD20 monoclonal antibody targeting B-lymphocytes) is an off-label medication for autoimmune cytopenias, including w-AIHA. It has been used as a second-line treatment before or after splenectomy with ongoing debate on which should be the first choice in second-line management.42,43 The decision is individualized based on patient’s age, comorbidities, and preference; several centers, especially pediatric ones, use rituximab as immediate second-line therapy before splenectomy. Adverse events may include reactions to infusion, hepatitis B reactivation, opportunistic infections, and on rare occasions progressive multifocal leukoencephalopathy. Long-term hypogammaglobulinemia has been observed after rituximab treatment of autoimmune cytopenias with consequent IVIG dependency (reported in 2 of 135 patients [∼1.5%] treated with rituximab for ITP).48 This complication may be more likely in patients with underline hypogammaglobilinemia49 or after repeated rituximab courses.50 A meta-analysis of 21 studies of rituximab use in patients with AIHA (standard dosing of 375 mg/m2 intravenously weekly for 4 weeks) concluded that the overall response rate (ORR) for 154 patients with w-AIHA was close to 70%, whereas the complete response rate evaluated within 2 to 4 months after treatment was 42%. Of 364 patients with w-AIHA or CAS who were evaluated for toxicity of rituximab, 38 adverse events were noted, mostly infusion related, and 1 case of opportunistic infection (Pneumocystis jiroveci pneumonia).51 Low-dose rituximab (100 mg fixed dose for 4 weekly infusions) was also studied as a second-line therapy in 23 patients with AIHA (14 with w-AIHA and 9 with CAS).44 The ORR for the patients with w-AIHA was 100% up to a year after treatment, with estimated relapsed-free survival at 2 years of 81%. Because the IgG-coated RBCs in w-AIHA are phagocytosed by the Fcγ receptor–carrying macrophages of the spleen, it is not surprising that splenectomy is effective for w-AIHA at least in short-term follow-up.42 Relapses are noted in 50% to 80% of patients in long-term (>2 years) follow-up, but frequently patients require a low dose of steroids (15 mg of prednisone per day or less) to maintain a Hb >10 g/dL.42 The increased risk of sepsis from encapsulated organisms (pneumococci, meningococci, and hemophilus influenzae) and of venous thromboembolism after splenectomy should be considered and discussed with the patients, especially to identify concurrent risk factors for infection or thrombosis. Immunizations preferably >6 weeks before splenectomy (which may be of suboptimal effect if the patient is in considerable steroid doses), medical evaluation for fevers after splenectomy and treatment with antibiotics is recommended. Pediatric recommendations include postsplenectomy prophylactic antibiotics. Thromboprophylaxis with low-molecular-weight heparin at least for the postoperative period is usually recommended for adults.42 As discussed above, in children, where w-AIHA is frequently a manifestation of an underlying immune dysregulation with varying degrees of immunodeficiency, the infectious risks after splenectomy or rituximab need to be strongly considered. Lessons that we learn from autoimmune cytopenias and primary immunodeficiency in children may expand to young adults because even monogenic PID disorders have a variable phenotype severity, and it is likely that less severe forms present after childhood. Therefore, a heightened awareness for such conditions is needed to follow the Hippocratic oath to “first do no harm.” If steroids cannot be weaned appropriately with consequent high risk of development of side effects (hypertension, drug-induced diabetes, osteoporosis, etc), a steroid-sparing medication with a low side effect profile will need to be added such as MMF or danazol.42,43,52 Recent pediatric experience with sirolimus in patients with autoimmune cytopenias and ALPS adds sirolimus as a consideration at this step.32,36,39
In the pre-rituximab era, azathioprine, 6-mercaptopurine, cyclosporine, and cyclophosphamide were used as second-line therapy; these medications are now reserved as third-line treatment due to inadequate data on efficacy and the high risk of side effects.42,43,53 High-dose cyclophosphamide and alemtuzumab (anti-CD52 monoclonal antibody targeting mature lymphocytes) have shown an efficacy of 60% to 80% in the few cases treated with these medications as a “last resort” due to their high-risk profile. Alemtuzumab has been especially effective (ORR, 92%) in 12 cases of CLL-associated w-AIHA.43 Hematopoietic stem cell transplant (HSCT) has been tried as treatment of patients with w-AIHA with rather disappointing results. Fourteen patients with refractory cytopenias (7 with w-AIHA, and 7 with Evans syndrome) were reported as transplant recipients by the Registry of the European Group of Blood and Marrow Transplantation; continuous remission was achieved only in 1 of 7 patients who had autologous HSCT and in 3 of 7 who had allogeneic HSCT, with a transplant-related mortality of ∼15%.54
w-AIHA is a chronic disease. Patients, even after response to steroids, have a >60% probability to relapse after steroid tapering and withdrawal.43,55 Further understanding of the pathogenesis and the variability of the disease will be necessary to optimally tailor individualized treatment strategies with the goal of optimal efficacy with the lowest possible short- and long-term toxicity.
Acknowledgment
The authors would like to acknowledge the Henry Loring Masters Foundation, Inc., established in memory of Henry, a young adult who died of AIHA at 25 years of age, with the goal to build awareness of the risks of death due to w-AIHA and support the need for further education and research.
Correspondence
Theodosia A. Kalfa, Division of Hematology, Cincinnati Children's Hospital Medical Center, 3333 Burnet Ave, MLC 7015, Cincinnati, OH 45229-3039; e-mail: theodosia.kalfa@cchmc.org.
References
Competing Interests
Conflict-of-interest disclosure: The author declares no competing financial interests.
Author notes
Off-label drug use: None disclosed.